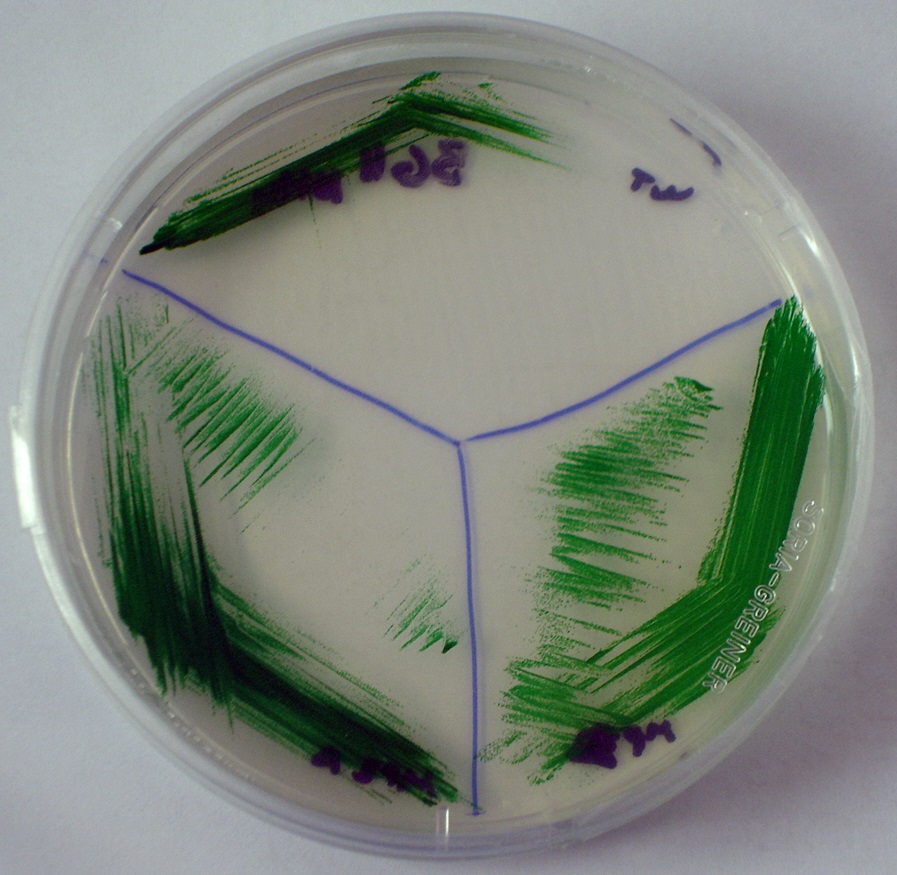

|
Breves21
Nuevos sensores garantizarán la seguridad de las edificaciones de por vida 20/02/2015Las edificaciones pueden verse afectadas por terremotos, corrimientos de tierras o defectos de construcción originales. Su derrumbe, en ocasiones catastrófico y con coste de vidas humanas, podría evitarse si en su construcción se instalasen sensores de alerta temprana. Con este objetivo, investigadores del proyecto europeo GENESI, han desarrollado un sistema sensor inalámbrico capaz de vigilar la seguridad de las grandes infraestructuras. En comparación con otras tecnologías, estas redes de sensores resultan baratas de instalar y mantener y, además, no son intrusivas. Asimismo, al contar con baterías, pueden instalarse en zonas apartadas en las que se carezca de suministro eléctrico y no dejan de funcionar aunque la red eléctrica no esté operativa, por ejemplo tras un terremoto. La tecnología ya ha sido validada en dos emplazamientos de construcción: la nueva línea B1 del metro de Roma y el Pont de la Poya sobre el Río Saane, en Friburgo (Suiza). Ahora se están planeando otros posibles usos para ella, como una instalación en el túnel de acceso a una central hidroeléctrica en Innertkirchen y una vía ferroviaria alpina vulnerable a los corrimientos de tierras. También se contempla aplicar los sensores al control de los numerosos monumentos públicos del patrimonio italiano e incluso a la delicada tarea de transportar obras de arte de un museo a otro. Más información Cordis
México abre un centro de reproducción de abejas por inseminación artificial 20/02/2015México ha puesto en marcha su primer Centro de Mejoramiento Genético de Abeja Reina, en la comunidad de Jaltomate (Aguascalientes), con el cual busca apoyar la productividad de 45 mil productores mexicanos de miel, que el año pasado generaron al país ingresos de 147 millones de dólares con sus exportaciones. El especialista José Rafael Limón Hernández, investigador del Centro, detalla que el proceso de inseminación consiste en que una vez anestesiada la abeja se abre el gancho ventral, en el que se inyectan alrededor de cuatro millones de espermatozoides provenientes del zángano. La nueva instancia científica tiene capacidad para realizar hasta 40 inseminaciones diarias, y a partir de este procedimiento se obtienen alrededor de 4 mil abejas reinas y de 8 a 10 mil abejas vírgenes, lo que contribuye a generar nuevas colmenas. El laboratorio cuenta con microscopios binoculares, estereoscopios y equipos para realizar prácticas a bajo costo para los productores, así como con tres especialistas certificados en inseminación artificial de abejas. El centro depende de la Secretaría de Agricultura, Ganadería, Desarrollo Rural, Pesca y Alimentación del gobierno mexicano. El Estado de Aguascalientes es el principal productor del país de miel de mezquite (rica en polen, de color amarillo muy claro casi blanco, de cristalización suave y fina, similar a la mantequilla). Más información AlphaGalileo
Redes sociales para ayudar a emergencias 19/02/2015La mayoría del personal de emergencias en Europa ve con buenos ojos la integración de los medios sociales en los procesos de gestión de su labor, según se extrae de una encuesta financiada por la Unión Europea. Estas actitudes varían en función del sexo, la edad y la procedencia. Por ejemplo, el personal femenino joven y aquellos radicados en países con una penetración elevada de las redes sociales son más propensos a expresar opiniones positivas. La encuesta, recién publicada y realizada en el marco del proyecto EMERGENT, se realizó entre 696 empleados de servicios de emergencias de 27 países europeos. Su principal función fue la de indagar en la opinión de los profesionales de los servicios de respuesta ante emergencias sobre los medios de comunicación sociales e identificar factores cruciales que influyen en el uso —tanto actual como futuro— de este tipo de medios en dichas organizaciones. La popularidad de las plataformas sociales ha cambiado de manera definitiva la comunicación. Durante las situaciones de crisis se generan comunidades ad hoc en torno a estos medios —por ejemplo mediante una página de Facebook o una etiqueta de Twitter— que proporcionan un medio valioso de difundir y compartir información relevante. Esto precisamente ocurrió en 2010 durante la catástrofe del Love Parade en Duisburgo (Alemania) y en 2012 con la llegada del Huracán Sandy a la costa este de los Estados Unidos. Suele ocurrir que estas comunidades no están conectadas con los servicios de emergencias y, por tanto, estos últimos no pueden recabar la información valiosa publicada en los medios sociales. A pesar de que en ocasiones se emplean aplicaciones sociales, por ejemplo en dispositivos móviles, para compartir apreciaciones y opiniones, estas están a penas comunicadas con los sistemas de gestión de emergencias existentes. El proyecto EMERGENT, iniciado en abril de 2014, espera descubrir modos de identificar e integrar información valiosa y fiable procedente de los medios sociales para beneficio de los procesos de gestión de emergencias y con la intención de proporcionar una respuesta mejor. El proyecto dio comienzo con un estudio de los impactos positivos y negativos de los medios sociales en situaciones de emergencia y analizó los comportamientos de los usuarios en estos medios durante dichas crisis. Su objetivo fue averiguar el modo en el que los servicios de emergencias podrían integrar estos nuevos canales de comunicación en sus procedimientos. Partiendo de una comprensión de la naturaleza de las situaciones críticas, en el análisis de los resultados se tendrán en cuenta las reacciones expresadas a través de medios sociales y cuáles son los medios sociales más utilizados. Para la investigación se están creando herramientas que refuerzan la comunicación entre los ciudadanos y los servicios de emergencias. Por ejemplo, para gestionar la enorme cantidad de información valiosa y distribuida, se utilizarán métodos nuevos de minería de datos con los que clasificar y catalogar la información disponible. También se ejecutarán evaluaciones de impacto, en forma de estudio de casos prácticos y análisis de anteriores situaciones de emergencia en las que los medios de comunicación sociales desempeñaron una función crucial. Los resultados de todos estos trabajos servirán para crear directrices de comunicación nuevas. La influencia de los medios de comunicación sociales en las emergencias se evaluará también mediante la participación continua de ciudadanos y representantes de los servicios de emergencia en talleres y en los propios medios sociales. El proyecto EMERGENT recibió 3,3 millones de euros de financiación europea y finalizará en marzo de 2017. Más información Cordis
Los neandertales se dividían algunas tareas por sexos 19/02/2015Las comunidades neandertales dividían algunas de sus tareas según su sexo. Esta es una de las principales conclusiones de un estudio elaborado por el Consejo Superior de Investigaciones Científicas (CSIC) y publicado en la revista Journal of Human Evolution. El trabajo ha analizado 99 dientes incisivos y caninos de 19 individuos de tres yacimientos diferentes (El Sidrón en Asturias, L’Hortus en Francia y Spy en Bélgica). Los análisis muestran que todos los individuos, independientemente de la edad, tenían estrías culturales, asociadas a su modo de vida, en las piezas dentales. “Esto se debe a la costumbre de estas sociedades, como ocurre en algunos pueblos actuales, de usar la boca como una tercera mano en tareas como la preparación de las pieles y el troceado de carne, por ejemplo”, explica el investigador del CSIC Antonio Rosas, del Museo Nacional de Ciencias Naturales. “Lo que hemos descubierto es que las estrías detectadas en los dientes de las mujeres adultas son más largas que las encontradas en los hombres adultos. Por eso suponemos que las tareas que realizaban eran diferentes”, puntualiza Rosas. Otras de las variables analizadas son los pequeños desconchones del esmalte dentario. Los individuos masculinos presentan mayor cantidad de mellas en el esmalte y la dentina de las piezas superiores, mientras que en los femeninos estas imperfecciones aparecen en las inferiores. No está claro aún qué actividades correspondían a las mujeres y cuáles a los hombres. Los autores del estudio apuntan que, al igual que en las sociedades cazadoras-recolectoras modernas, las mujeres podrían haberse encargado de la preparación de las pieles y la elaboración de las vestimentas. El retoque de los filos de las herramientas de piedra, explican, parece haber sido una tarea masculina. “A pesar de todo, creemos que la especialización del trabajo según el sexo probablemente se limitase a unas pocas tareas, ya que es posible que tanto hombres como mujeres participasen de igual manera en la caza de grandes animales”, añade Almudena Estalrrich, del Museo Nacional de Ciencias Naturales. “El estudio de los neandertales ha aportado numerosos descubrimientos en los últimos años. Hemos pasado de pensar en ellos como seres poco evolucionados, a saber que cuidaban a los enfermos, enterraban a sus muertos, comían marisco e, incluso, tenían características físicas distintas a las esperadas: los había pelirrojos, y de tez y ojos claros. Hasta ahora pensábamos que la división sexual del trabajo era típica de las sociedades sapiens, pero eso parece que no es así”, concluye Rosas. Más información CSIC
Un ‘botiquín’ natural que podría salvar a las abejas 18/02/2015La nicotina no es saludable para las personas, pero se ha descubierto que este y otros productos químicos naturales presentes en la flor del tabaco y otras plantas pueden sanar a abejas enfermas. Según un estudio dirigido por la Universidad de Dartmouth (EEUU), en el néctar de estas flores hay sustancias –además de la nicotina, otros alcaloides como la anabasina, el glucósido iridoide catalpol o el terpenoide timol- que reducen significativamente las infecciones por parásitos. En general, ya se sabía que las plantas producen sustancias químicas llamadas metabolitos secundarios con los que defienden sus hojas contra los herbívoros. Estos productos químicos también se encuentran en el néctar que liban los polinizadores, pero se desconocía su impacto en los insectos. Los investigadores norteamericanos analizaron este punto, en concreto con abejorros a los que se les inoculó un parásito intestinal. Se descubrió así que el consumo de estos productos químicos disminuía la intensidad de la infección en hasta un 81%. Estos resultados sugieren que plantas que crecen con alto contenido de estos compuestos en los alrededores de las granjas podrían constituir un auténtico “botiquín” natural que mejore la supervivencia de las abejas y, con ellas, la polinización de los cultivos. Más información Redacción T21
Nueva plataforma de software en la nube para el diseño de fármacos 18/02/2015Mind the Byte, una pequeña empresa con sede en el Parque Científico de Barcelona, anunció ayer que va a abrir de manera gratuita iMols, la primera plataforma en la nube especialmente diseñada para el descubrimiento de fármacos en la modalidad SaaS (software como servicio), a la comunidad científica, académica y empresarial. El portal ofrece la posibilidad de acceder sin ningún coste a sistemas de procesamiento intensivo de datos y aplicaciones de software científico-técnico de última generación para el diseño de fármacos. Investigadores y empresas podrán navegar por bibliotecas públicas, buscar moléculas y proteínas, gestionar quimiotecas y proteotecas, hacer perfilados y cribado virtual de moléculas en menos de cinco minutos, y compartir toda la información con el propio grupo de investigación. La herramienta también permite ejecutar aplicaciones desde cualquier lugar y dispositivo conectado a la red, al mismo tiempo que garantiza un entorno seguro de trabajo mediante una estricta limitación de los servicios (sólo permite compartir la información que se sube y se gestiona a la plataforma con los miembros del equipo), una infraestructura certificada y otras medidas de seguridad como la encriptación de todas las transferencias de datos. iMols sigue la filosofía SaaS, según la cual el usuario puede acceder a las aplicaciones alojadas en la nube de manera automática en función de sus necesidades puntuales, lo que permite escalar recursos computacionales según la demanda de la organización. Más información SINC
Matemáticas para comprender la anatomía de la cabeza humana 17/02/2015Una nueva herramienta de análisis matemático desarrollada por investigadores del Grupo de Biología Teórica del Institut Cavanilles de Biodiversitat i Biologia Evolutiva de la Universitat de València ha permitido una comprensión más profunda de la anatomía de la cabeza humana gracias a la descripción de una red ampliada del cráneo estructurada en diez módulos. Los resultados de este estudio liderado por el investigador Diego Rasskin Gutman se publican en el último número de la revista ‘Scientific Reports’, editada por ‘Nature’. Los científicos de la Universitat de València han creado un marco de investigación basado en herramientas de análisis matemático de redes para el estudio de la anatomía, denominada Anatomical Network Analysis (AnNA). En concreto, este método se ha elaborado durante los últimos seis años, fruto de los resultados de la tesis doctoral de Borja Esteve Altava, bajo la dirección de Rasskin. Gracias al alto poder de abstracción de AnNA, los investigadores han llevado a cabo numerosos estudios tanto del esqueleto humano como del resto de los vertebrados terrestres, en particular del desarrollo y la evolución del cráneo. Más información AlphaGalileo
Crean una insulina 'inteligente', que se autoactiva cuando el azúcar en sangre se eleva 17/02/2015Para mitigar los peligros inherentes a las inyecciones de insulina de los diabéticos, científicos de la Universidad de Utah (Estados Unidos) han creado Ins-PBA-F, una insulina "inteligente" de larga duración que se autoactiva cuando el azúcar en la sangre se eleva. Las pruebas en modelos de ratón para la diabetes tipo 1 muestran que una inyección dura un mínimo de 14 horas, tiempo durante el cual puede bajar en varias ocasiones y de forma automática el azúcar en la sangre después de que a los ratones se les den cantidades de azúcar comparables a las que consumirían a la hora de comer. El equipo de Utah seguirá evaluando la seguridad a largo plazo y la eficacia de Ins-PBA-F. El derivado de insulina podría llegar a la Fase 1 de pruebas clínicas en humanos dentro de dos a cinco años. Actualmente hay varias insulinas inteligentes en desarrollo, que suelen incorporar una barrera a base de proteínas, tal como un gel o un revestimiento, que inhibe la insulina cuando el azúcar en la sangre es bajo. Sin embargo, tales componentes de base biológica a menudo son habitualmente fuente de problemas, provocando efectos secundarios no deseados tales como una respuesta inmune. Ins-PBA-F difiere de éstas en que fue creada modificando directamente la estructura química de la insulina. Más información Universidad de Utah/T21
La comunidad científica afronta el reto de salir del aislamiento académico 16/02/2015Una encuesta realizada por el Pew Research Center, en colaboración con la American Association for the Advancement of Science (AAAS), en la que se ha entrevistado a 3.748 científicos estadounidenses, revela que la comunidad científica se enfrenta a cambios que incluyen, entre otras cosas, salir del aislamiento académico y ser más protagonista en la sociedad. Todo ello, para hacer sus proyectos más visibles en momentos en los que hay dificultades para lograr financiación. Según la encuesta, el 87% de los científicos opina que debe ser más activo en los debates de políticas públicas. El 43% que un mayor protagonismo en los medios de comunicación y en las noticias puede ser positivo para sus carreras. En 2009, este porcentaje solo era del 37%. En el escrutinio, el 71% cree que el público tiene algo o mucho interés en su área de investigación y el 53% dice que hay bastante debate en las noticias sobre su campo de estudio. Asimismo, el 22% de los científicos de la AAAS considera que es "muy importante" (4%) o "importante" (18%) para la promoción profesional en su disciplina promover sus hallazgos en las redes sociales como Facebook o Twitter. Al mismo tiempo, el 79% considera negativo las noticias no distingan entre los hallazgos científicos bien fundamentados y los que no lo están. Además, el 52% dice que la simplificación de los descubrimientos en investigación supone un grave problema para la ciencia. Más información SINC
El LHC se prepara para comprender la materia oscura 16/02/2015El Gran Colisionador de Hadrones (LHC) del CERN (Laboratorio Europeo de Física de Partículas, Ginebra, Suiza) podría hacer este año un descubrimiento que ayude a comprender la materia oscura, según los investigadores. El LHC -que permitió comprobar la existencia del bosón de Higgs- empezará en unos meses su segundo periodo de tres años de funcionamiento tras dos años de descanso, en los cuales se ha duplicado su potencia. Según informa Phys.org, un nuevo descubrimiento "podría tener lugar tan pronto como este año... si somos muy afortunados", en palabras de Beate Heinemann, profesora de física en la Universidad de California en Berkeley y miembro del equipo de investigación Atlas, del LHC. "Tal vez encontraremos materia supersimétrica. Para mí es más emocionante que el bosón de Higgs". La supersimetría es una extensión del modelo estándar de la física. Según ella, todas las partículas tienen una contraparte más pesada, y los expertos creen que si estas partículas compañeras están ahí, el LHC debería ser capaz de encontrarlas. El modelo estándar por sí solo no puede explicar la existencia de la materia oscura, que se cree que mantiene unidas a las galaxias y representa la mayor parte de la materia del universo. Redacción T21
Cada año, entre cinco y trece millones de toneladas de basuras de plástico terminan en los océanos de todo el mundo 13/02/2015 Sus cálculos estiman que, ese año, los desperdicios plásticos de dichos países ascendieron a 275 millones de toneladas. De ellas, acabaron en el mar entre 4,8 y 12,7 millones de toneladas de plástico, procedentes de las personas que viven a 50 kilómetros de la costa. Para dar una idea de lo que esto supone, “ocho millones de toneladas es el equivalente a encontrar cinco bolsas de supermercado llenas de plástico cada 30 centímetros de costa en los 192 países examinados", subraya Jenna Jambeck, autora principal del estudio e investigadora de la Universidad de Georgia en una información recogida por la plataforma Sinc. SINC
Un exoesqueleto utiliza la realidad virtual para rehabilitar a personas con lesiones medulares o ictus 13/02/2015Un prototipo de exoesqueleto, que realiza una estimación de alta precisión de la postura del brazo en tiempo real y emplea la realidad virtual para recrear situaciones cotidianas, está siendo probado por 10 pacientes con lesión medular del Hospital de Parapléjicos de Toledo. La innovación ha sido desarrollada en el marco del proyecto europeo Hyper, que cuenta con fondos de cinco millones de euros para desarrollos de realidad virtual, neuroprotésica y neurorrobótica. Se trata de la principal investigación en curso en este ámbito en España, y en ella participa la Alianza de Investigación vasca IK4 bajo la coordinación del Consejo Superior de Investigaciones Científicas (CSIC). En marcha desde 2010, el proyecto ha dado lugar al desarrollo de un conjunto de sistemas innovadores que facilitan nuevas terapias de rehabilitación y nuevos sistemas de compensación de la marcha en pacientes con lesiones medulares o infartos cerebrales (ictus). El centro Vicomtech-IK4 ha sido responsable de explorar el potencial de la realidad virtual en el proyecto, mientras que IK4-Cidetec se ha encargado de desarrollar los sensores que se insertan en las prótesis y miden la presión para responder con naturalidad al movimiento ordenado por el paciente. La principal ventaja de estas herramientas radica en que permitirán que los procesos de rehabilitación comiencen más temprano, se lleven a cabo de una forma más intensiva y amena para el paciente, y contribuyan a una recuperación más rápida y completa. Los sistemas diseñados facilitan también un análisis cuantitativo de los avances que hacen los pacientes. Más información IK4
Los tornados serán comunes a finales del siglo XXI como consecuencia del cambio climático 12/02/2015Los tornados serán comunes para el año 2080 como consecuencia del cambio climático, señala un estudio de la Universidad de Georgia (EEUU). En él, se utilizaron modelos climáticos para examinar patrones climáticos severos del pasado, como tornados, tormentas de granizo o potentes vientos; y se hicieron proyecciones de lo que sucedería a continuación. Se descubrió que, si los humanos continúan emitiendo carbono a la atmósfera, hay que esperar que el clima se vuelva más severo a finales del siglo XXI. En cuanto a los tornados, los científicos compararon la actividad de estos entre 1980 y1990, para proyectar la actividad que tendrían entre los años 2080 2090. Las proyecciones señalaron que “es probable que las inclemencias climáticas severas se sucedan con más frecuencia en los próximos 60 años", y que lo hagan de manera variable, con años con muchos tornados y otros años con muy pocos. Más información Redacción T21
La nave IXV, de la ESA, completa con éxito su misión de reentrada en la atmósfera terrestre 12/02/2015El vehículo experimental creado para que Europa adquiera en el futuro la capacidad de reentrar en la atmósfera terrestre con un sistema de transporte reutilizable ha completado su misión con éxito. El avión de la ESA IXV -siglas en inglés de Vehículo Experimental Intermedio- ha llevado a cabo una reentrada perfecta, amerizando en el océano Pacífico al oeste de las islas Galápagos El avión IXV despegó ayer desde el Puerto Espacial Europeo de Kourou, en la Guayana Francesa, en un lanzador europeo Vega. Se separó del cohete a una altura de 348 km y continuó su ascenso hasta alcanzar los 413 Km. Durante su reentrada tomó una gran cantidad de datos, gracias a los más de 300 sensores con que está equipado. Durante el descenso, el avión – de cinco metros de largo y dos toneladas de peso- redujo su velocidad de hipersónica a supersónica. La velocidad de reentrada, de 7,5 Km/segundo a una altura de 120 Km, reprodujo las mismas condiciones a las que estaría sometida una nave que volviera a Tierra desde una órbita baja. IXV planeó a través de la atmósfera antes de desplegar el paracaídas que frenaría aún más su velocidad de caída, hasta el amerizaje seguro en el océano Pacífico. La nave se mantuvo a flote con flotadores hinchables, mientras el barco de rescate se apresuraba a recogerlo. Una vez en Europa, en el centro tecnológico de la Agencia Espacial Europea, Estec (Países Bajos), el IXV será sometido a un análisis detallado. Dominar la técnica de la reentrada es una habilidad indispensable a la hora de desarrollar lanzadores con etapas reutilizables, para traer a Tierra muestras de otros planetas o para la vuelta a casa de los astronautas. Será igualmente importante para la futura investigación en observación de la Tierra y microgravedad, y en misiones de mantenimiento y retirada de satélites. Los resultados iniciales de esta misión se harán públicos, previsiblemente, dentro de unas seis semanas. Este lanzamiento también ha permitido mostrar la gran capacidad del nuevo lanzador Vega, y para confirmar su flexibilidad para un amplio rango de misiones. Más información ESA
Arranca en Málaga el IV Foro Europeo para la Ciencia, Tecnología e Innovación 11/02/2015
Foro Transfiere, el 4º Foro Europeo para la Ciencia, Tecnología e Innovación, ha abierto hoy sus puertas en el Palacio de Ferias y Congresos de Málaga (Fycma). El mayor evento existente en España centrado en la transferencia de conocimiento entre investigadores y empresas, reúne a más de 450 entidades públicas y privadas y cuenta con la presencia de 26 países en su edición más internacional.
Transfiere alcanza su cuarta edición consolidado como el principal evento español centrado en la transferencia de conocimiento entre investigadores y empresas, con un programa altamente especializado donde más de 130 expertos internacionales abordan las tendencias y oportunidades en innovación desde la óptica del emprendimiento, el papel dinamizador de las plataformas tecnológicas y la internacionalización de los proyectos. En esta convocatoria, además, se superan ampliamente todos los datos de 2014 con más de 450 entidades; 220 grupos de investigación y 50 universidades, 42 stands y más de 4.200 citas previstas. En total, Transfiere 2015 reúne a más de 2.000 profesionales procedentes de empresas multinacionales y pymes, administraciones públicas, universidades y centros de investigación universitarios, Organismos Públicos de Investigación (OPIS) y centros tecnológicos, plataformas tecnológicas, centros europeos de empresas innovadoras (CEEIS), clusters y parques científicos y tecnológicos. Esta edición es la más internacional hasta el momento, con representantes de 26 países, entre los que se encuentran Alemania, Argentina, Brasil, Bélgica, Colombia, Corea del Sur, Dinamarca, Ecuador, Estados Unidos, España, Finlandia, Francia, India, Irán, Israel, Malasia, Marruecos, México, Panamá, Paraguay, Perú, Polonia, Portugal, Puerto Rico, Reino Unido, Rusia y Suiza. Más información Redacción T21
Observan dos estrellas sorprendentemente masivas a punto de fusionarse antes de explotar 11/02/2015 ESO
El primer material magnético conocido por el ser humano desvela uno de sus secretos 11/02/2015La magnetita es el primer material magnético que conoció el ser humano ya hace miles de años. Sin embargo, las propiedades magnéticas de la superficie de este material son, todavía hoy, objeto de discusión entre los científicos. Investigadores del Consejo Superior de Investigaciones Científicas (CSIC) y del sincrotrón ALBA de Barcelona han determinado el momento magnético de la magnetita en su superficie. El momento magnético es una propiedad básica relacionada con la fuerza de su campo magnético y que está ligada con su efectividad para actuar como filtro de electrones separándolos en función de su espín. Este hallazgo, publicado en la revista Physical Review B, ha permitido demostrar que el momento magnético de átomos que se encuentran en la superficie de la magnetita no se corresponde con el que tienen los átomos del interior de este material. Dicha información será de utilidad, según los científicos, para crear dispositivos que permitan manipular el espín del electrón para el almacenamiento y la manipulación de información. “Nuestro próximo objetivo es modificar de forma controlada y reversible los átomos de la superficie de la magnetita para observar el efecto en el momento magnético. De este modo, podríamos manipularlo a nuestra voluntad”, indica Juan de la Figuera, investigador del CSIC en el Instituto de Química-Física Rocasolano. Se trata del primer trabajo de estas características en el que se emplea el único microscopio de fotoelectrones que existe en España, situado en el sincrotrón ALBA de Barcelona. Más información CSIC
Descubren nuevos mecanismos de regulación del ritmo circadiano de las cianobacterias 10/02/2015Investigadores de la Universidad de Alicante y de la Universidad de San Diego, en California, han descubierto mecanismos de regulación que permiten la comunicación entre las señales ambientales y las moléculas que controlan el ritmo circadiano, el reloj interno de animales y plantas, a fin de optimizar procesos metabólicos y fotosintéticos. Los ciclos de luz y oscuridad (día y noche) tienen una enorme importancia para las especies y la actividad de la vida en la tierra. Las cianobacterias fueron pioneras en desarrollar un reloj interno para adaptarse, e incluso anticipar los ciclos de luz y oscuridad. Se trata de los microorganismos que crearon la atmósfera de oxígeno del planeta y posibilitaron la vida tal y como la entendemos actualmente. Realizan, de forma más eficiente, el mismo tipo de fotosíntesis que las plantas, consumiendo CO2, y tienen por tanto enorme importancia evolutiva y ecológica, y un gran potencial biotecnológico. Para llevar a cabo este estudio, los científicos han trabajado con el organismo modelo de cuyo reloj circadiano más detalles moleculares se conocen, que es la cianobacteria Synechococcus elongatus PCC7942, utilizada en laboratorios de todo el mundo. Una de las aplicaciones prácticas del estudio puede ser la producción de combustible biofuel de forma más asequible. Más información UA/T21
Presentan un todoterreno eléctrico con un pequeño motor térmico 10/02/2015El Instituto Universitario de Investigación del Automóvil (Insia) de la Universidad Politécnica de Madrid (UPM) ha fabricado Innvextran, un vehículo de tracción eléctrica que, mediante un pequeño motor térmico, supera la escasa autonomía de las baterías. Frente a las soluciones de este tipo más extendidas, consistentes en plantas puramente eléctricas o en configuración en paralelo, la propuesta de la UPM consiste en incorporar a este tipo de vehículos un tren de tracción en configuración híbrida de serie. De este modo, se puede asegurar el funcionamiento puramente eléctrico en determinadas zonas para adecuarse a las exigencias medioambientales y garantizar, asimismo, la autonomía necesaria para la aplicación correspondiente, mediante un motor-generador desacoplado de la tracción mecánica. El prototipo surgido del proyecto, actualmente pendiente de su legalización y posterior industrialización, presenta la forma de un todoterreno, informa el Instituto de la Ingeniería de España. El vehículo fue presentado en el último Salón del Automóvil de Madrid. Más información UPM/IIE/T21
Europa busca soluciones para el "reto del agua" 09/02/2015El invierno europeo puede parecer en ocasiones una cadena interminable de días lluviosos. Así, resulta increíble que, entre tanto aguacero, exista escasez de agua y que las sequías sean un fenómeno cada vez más frecuente y generalizado en la Unión Europea. Grandes extensiones del sur, el oeste e incluso el norte de Europa sufrieron sequías en 2011 y 2012. La sequía de 2011 fue la más intensa en cien años, con precipitaciones un 40 % por debajo de lo normal. La disponibilidad de agua en esos dos años fue considerablemente menor en primavera y se llegaron a establecer restricciones al suministro en amplias zonas de la UE. En 2007, al menos el 11 % de la población de la UE y el 17 % de su superficie experimentaron escasez de agua, un fenómeno que no deja de empeorar, hasta el punto de que una buena proporción de las cuencas fluviales se encuentran bajo estrés hídrico en todas las épocas del año. Esta escasez es más intensa durante los meses estivales en el sur de Europa, una tendencia que se viene acentuando en cuencas septentrionales de países como el Reino Unido y Alemania. El reto del agua no puede contemplarse como un hecho aislado, pues se verá agravado por la creciente demanda de alimentos, materiales y energía, además de por el cambio climático. Por ejemplo, un aumento del consumo energético incrementa la necesidad de contar con más agua para la refrigeración de las centrales termoeléctricas, mientras que las opciones alternativas, como la producción de biomasa con fines energéticos (biocombustibles), también podrían intensificar la ocupación del suelo y el consumo de agua. En Horizonte 2020, la subconvocatoria «Innovación hídrica: impulsar su valor para Europa» (Water Innovation: Boosting its value for Europe) cuenta con varios temas de investigación que podrían ayudar a combatir los retos hídricos tanto actuales como venideros. Está dividida en «fase uno» y «fase dos» e incluye temas como el desarrollo de sistemas, tecnologías y herramientas relacionadas con el abastecimiento hídrico y el saneamiento, y metodologías y soluciones de gestión hídrica para sectores como el agrícola. Investigadores de toda Europa estudian ya distintas soluciones para el reto del agua. La edición de esta semana de CORDIS Express presta atención a la labor que se está llevando a cabo y otras noticias afines. Cordis
|
|
||||||
|
|||||||

 Tendencias Científicas
Tendencias Científicas

CIENCIA ON LINE
CIENCIA ON LINE